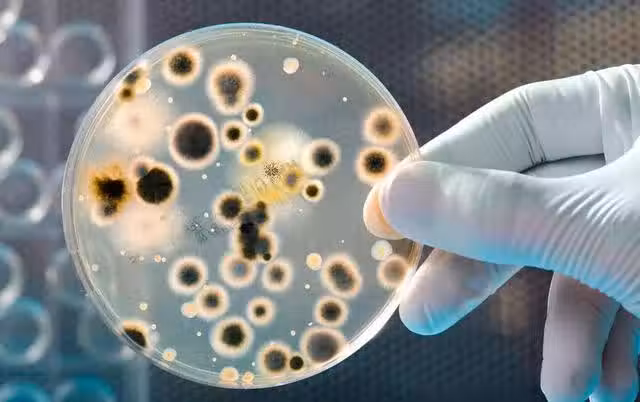

16/16
下一頁
建議大家:衛生間這4樣「晦氣之物」要扔掉,可惜很多人都捨不得
16/16
正常來說,馬桶坐墊是需要兩三天就清潔一次的,也需要及時的更換,只有這樣才能夠保證乾淨衛生,使用的時候更放心。
總結:
不管你家衛生間多大,以上這些東西都需要及時的扔掉,真的不是迷信,大家學到了嗎?
總結:
不管你家衛生間多大,以上這些東西都需要及時的扔掉,真的不是迷信,大家學到了嗎?
 幸山輪 • 16K次觀看
幸山輪 • 16K次觀看 喬峰傳 • 3K次觀看
喬峰傳 • 3K次觀看 許夢可 • 2K次觀看
許夢可 • 2K次觀看 許夢可 • 320次觀看
許夢可 • 320次觀看 舒黛葉 • 380次觀看
舒黛葉 • 380次觀看 管輝若 • 3K次觀看
管輝若 • 3K次觀看 幸山輪 • 310次觀看
幸山輪 • 310次觀看 管輝若 • 1K次觀看
管輝若 • 1K次觀看 喬峰傳 • 350次觀看
喬峰傳 • 350次觀看 管輝若 • 2K次觀看
管輝若 • 2K次觀看 舒黛葉 • 790次觀看
舒黛葉 • 790次觀看 舒黛葉 • 550次觀看
舒黛葉 • 550次觀看 花伊風 • 240次觀看
花伊風 • 240次觀看 花伊風 • 270次觀看
花伊風 • 270次觀看 管輝若 • 870次觀看
管輝若 • 870次觀看 喬峰傳 • 5K次觀看
喬峰傳 • 5K次觀看 管輝若 • 9K次觀看
管輝若 • 9K次觀看 喬峰傳 • 610次觀看
喬峰傳 • 610次觀看 喬峰傳 • 1K次觀看
喬峰傳 • 1K次觀看 幸山輪 • 70次觀看
幸山輪 • 70次觀看 花伊風 • 200次觀看
花伊風 • 200次觀看 舒黛葉 • 410次觀看
舒黛葉 • 410次觀看 呂純弘 • 4K次觀看
呂純弘 • 4K次觀看 管輝若 • 730次觀看
管輝若 • 730次觀看






















